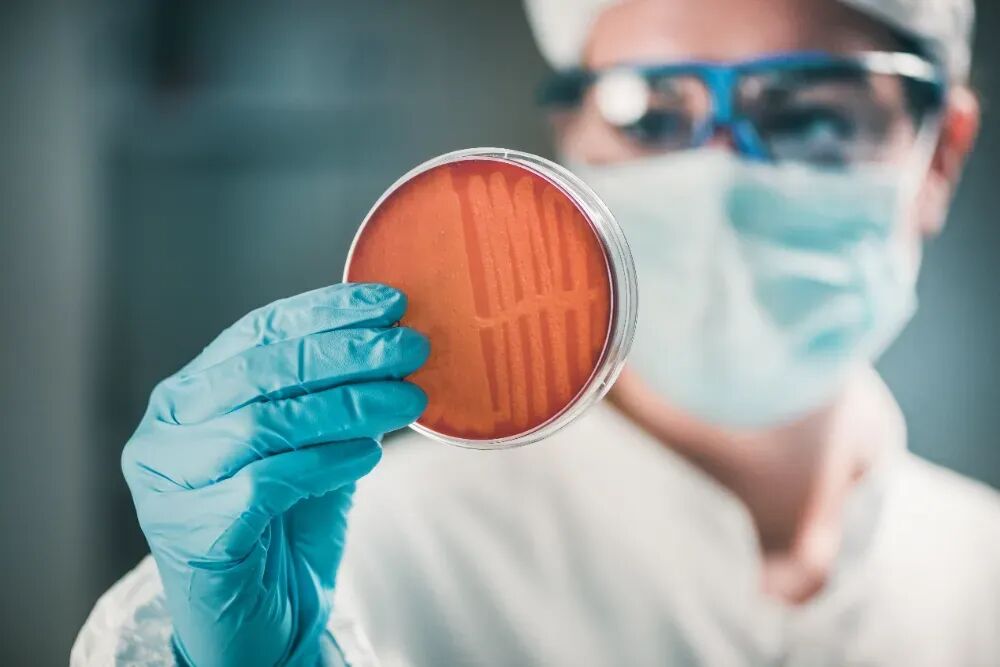

警惕!血液里检出这些“永久化学物”,竟来自你每天吃的果蔬
来源:CHTV百姓健康2026-01-19 08:06:01
我们每天呼吸的空气、饮用的水、食用的食物,乃至日常接触的塑料制品,都在悄然将数百种化学物质带入体内。这些看不见的“隐形访客”是否正在悄悄影响我们的健康?一项由中国科研团队主导的迄今国内最大规模的人群血清环境暴露图谱研究,首次系统揭示了人体内化学物暴露的全景图,并明确指出:环境暴露不仅是慢性病的重要诱因,其风险甚至在不同地区、年龄和人群中呈现出显著差异。

如果有一天,你的血液化验单上出现β-HCH、p,p’-DDE、PFASs 这些陌生的化学名词,千万别不当回事——它们不是无关紧要的符号,而是藏在你身体里的“健康隐患”。
这些到底是什么?其实都是常见的农药及环境化学残留:β-HCH是早已禁用的“六六六”农药中,毒性最强、最难分解的成分;p,p’-DDE是当年广泛使用的“滴滴涕”杀虫剂,在人体内难以代谢的残留产物;而PFASs是一类难降解的“永久化学物”,在自然环境和人体内的分解速度极慢,易长期累积!
《Nature Communications》杂志曾发表过一项让人震惊的研究:科学家检测了中国15个省份5696人的血清,在267种环境化学物质里,有74种高频检出。其中,有机氯农药和全氟化合物不仅长期“驻扎”在血液中,还和高血压、糖尿病等12种慢性病明确相关。更让人忧心的是,其中PFASs、β-HCH等物质在部分受测者体内的含量已超过世界卫生组织(WHO)制定的安全阈值,而它们的来源广泛,其中最易接触到的,就是你每天端上餐桌的果蔬!

你的身体里,藏着多少农药残留?
研究团队依托持续二十多年的中国营养与健康调查(CHNS,1991-2021)数据,在全国范围内采集血清样本,完成了环境化学物浓度检测,建成了目前全球样本量最大的中国人群血清环境化学物暴露数据库。数据显示,农药残留在人体内的累积,受地域、年龄、性别影响很大。
地域差异:东部沿海比内陆高3倍
地域是影响人体化学暴露水平的关键因素。以上海、浙江为代表的东部沿海地区,居民血清中全氟烷基物质(PFASs)的浓度,比陕西、贵州等内陆地区高出3倍以上。这大概率和工业发展水平有关——长江三角洲是我国工业重镇,当地居民体内PFASs、多氯联苯(PCBs)等工业污染物的累积量明显更高。研究者推测,工业废水排放、大气沉降等会带来这些持久性有机污染物,它们无法被有效去除,会通过食物链一步步累积到人体中。
年龄累积:70岁老人体内残留是年轻人的8倍
年龄是仅次于地域的重要影响因素。数据显示,70岁以上人群血液中β-HCH的浓度达到0.313ng/mL,是20-30岁人群的5倍;p,p’-DDE浓度为1.91ng/mL,更是年轻人的8倍。而全氟化合物的浓度在50岁人群中达到峰值,这和代谢综合征的高发年龄段刚好吻合。
性别差异:男女体内残留成分不同
性别也会影响化学物质的累积。女性体内有机氯农药(OCPs)水平明显高于男性,这可能和女性体脂比例较高有关——这类农药是脂溶性的,容易在脂肪里“藏起来”;而男性体内PFASs和邻苯二甲酸盐水平更高,大概率和职业暴露、身体代谢差异有关。
从肠道到全身:农药如何悄悄伤害你?
俄亥俄州立大学研究团队在《肠道微生物》期刊(2021年)发表的体外实验结果显示,发现了农药伤害健康的另一条隐秘路径——扰乱肠道菌群。哪怕是低剂量的农药暴露,也会显著改变肠道菌群的组成和代谢活动,进而引发全身连锁反应。
肠道“微生态”被打乱
以常见的有机氯农药4,4'-DDE为例,它会专门抑制肠道里拟杆菌(Bacteroides ovatus)的生长。这种细菌是肠道里的“有益菌”,能分泌短链脂肪酸(SCFAs)来维持肠道屏障的完整性。一旦拟杆菌被抑制,肠道屏障就会变得“通透”,脂多糖等有害物质会趁机进入血液;同时短链脂肪酸减少,会影响免疫调节功能,还会导致胆汁酸代谢异常,进而干扰肝脏的脂质代谢。
连锁反应:全身健康都受影响
肠道菌群被扰乱后,一系列健康危机随之而来:
内分泌干扰:部分农药会干扰内分泌系统,影响甲状腺激素、性激素的代谢,可能诱发肥胖、生殖系统疾病。
更需要警惕的是,研究发现肠道细菌会吸附农药并在体内累积,延长其在体内的停留时间。哪怕后续停止接触农药,这些藏在菌群里的化学物质仍会持续释放,造成长期危害。

这些果蔬,是农药残留“重灾区”
韭菜:曾是农药残留“重灾区”,主要超标农药是腐霉利。按旧标准(0.2mg/kg),超标率高达15.97%。韭菜喜欢潮湿环境,容易滋生病害,种植时往往会超量使用杀菌剂。不过2023年新标准将限量值放宽至5.0mg/kg,超标率已降至2.21%;
此外,很多热带水果生长周期长、病虫害多,农药使用量更大,再加上运输、存储环节可能出现的二次污染,残留风险会进一步攀升。

3步搞定!降低农药残留风险
第一步:科学清洗,针对性去除表面残留
不同农药的溶解性不同,清洗方法也不一样,找对方法才能有效去除:
顽固残留:先焯水1-2分钟,能去除大部分脂溶性农药,不过会损失少量水溶性维生素。
发酵转化:泡菜、腌菜等发酵过程中,乳酸菌能降解部分农药。比如豇豆经发酵后,灭蝇胺残留可减少40%。
查看认证标识:绿色食品、有机食品对农药使用有严格规范,残留风险更低;
饮食多样化:不同食物的农药残留种类不同,多样化摄入能避免单一农药的过量累积。

结语
血液中的化学残留,是环境与饮食在我们身体上留下的印记,也提醒着我们:健康从来不是孤立的选择,而是与每一口食物、每一次消费紧密相关。了解农药残留的风险,不是为了让我们对果蔬望而却步,而是学会用科学的方法为健康“把关”——认真清洗、合理加工、聪明选购,这些简单的行动就能有效降低暴露风险。更重要的是,当我们优先选择绿色、有机食品时,也是在为推动绿色农业、净化生态环境助力。从餐桌的小细节到生活的大选择,每一份理性的健康坚守,都是在为自己和下一代筑牢安全防线。
参考资料:
[1]YOU L, KOU J, WANG M,et al. An exposome atlas of serum reveals the risk of chronic diseases in the Chinese population[J]. Nat Commun, 2024;15(1):2268. DOI: 10.1038/s41467-024-46595-z.
[2]LI C, ZHU H, LI C,et al. The present situation of pesticide residues in China and their removal and transformation during food processing[J]. Food Chem, 2021;354:129552. DOI: 10.1016/j.foodchem.2021.129552.
[3]CHEN L, YAN H, DI S,et al. Mapping pesticide-induced metabolic alterations in human gut bacteria. bioRxiv [Preprint]. 2024:2024.11.15.623895. DOI: 10.1101/2024.11.15.623895. Update in: Nat Commun. 2025 May 10;16(1):4355. DOI: 10.1038/s41467-025-59747-6.
[4]曾静, 乔雄梧. 我国近年蔬菜水果中农药残留超标状况浅析[J].农药学学报, 2023, 25(6): 1206-1221. DOI: 10.16801/j.issn.1008-7303.2023.0091.
[5]叶云霞, 赵英杰. 去除果蔬农药残留方法的研究现状[J]. 农机使用与维修, 2024, (8): 119-122. DOI: 10.14031/j.cnki.njwx.2024.08.034.
[6]陆治名,韩丹丹,孟凡轩,刘卓凡. 果蔬中农药残留研究进展[J]. 医学研究与教育,2018, 35(1): 70-75. DOI: 10.3969/j.issn.1674-490X.2018.01.015.

 CHTV 百姓健康微信
CHTV 百姓健康微信